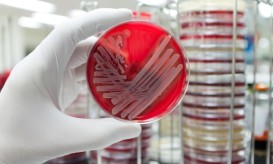

Χρυσίζων σταφυλόκοκκος: Τι πρέπει να γνωρίζουμε για το επικίνδυνο βακτήριο
Πώς μπορεί από το δέρμα ή τη μύτη να φτάσει σε όλο το σώμα, προκαλώντας επικίνδυνες επιπλοκές.

Πώς μπορεί από το δέρμα ή τη μύτη να φτάσει σε όλο το σώμα, προκαλώντας επικίνδυνες επιπλοκές.

Τα βακτήρια του σταφυλόκοκκου μπορούν να εξαπλωθούν μέσω μολυσμένων επιφανειών και από άτομο σε άτομο. Τα παιδιά μπορούν να...

Ο σταφυλόκοκκος (Staphylococcus) είναι ένα είδος βακτηρίων που μπορεί να προκαλέσει πολλά είδη λοιμώξεων στο σώμα σας. Πρόκειται για...

Ο σταφυλόκοκκος είναι μια ομάδα βακτηρίων που μπορεί να προκαλέσει μια σειρά μολυσματικών ασθενειών σε διάφορους ιστούς του σώματος.

Ο σταφυλόκοκκος μπορεί να εκδηλωθεί με μια ποικιλία συμπτωμάτων που κυμαίνονται από μικρά προβλήματα του δέρματος μέχρι και ενδοκαρδίτιδα,...

Πολλοί άνθρωποι μεταφέρουν βακτήρια σταφυλόκοκκου, αλλά ποτέ δεν αναπτύσσουν λοιμώξεις από τον ιό. Ωστόσο, αν αναπτύξετε μια μόλυνση από...

Ο σταφυλόκοκκος μπορεί να εκδηλωθεί με μια ποικιλία συμπτωμάτων που κυμαίνονται από μικρά προβλήματα του δέρματος μέχρι και ενδοκαρδίτιδα,...
Μια νέα κατηγορία συνθετικών αντιβιοτικών ικανών να καταστρέψουν τα ανθεκτικά στα αντιβιοτικά βακτήρια του χρυσίζοντος σταφυλόκοκκου (MRSA), ανακάλυψε ένας...

Επιστήμονες στις ΗΠΑ ανακάλυψαν πάνω στο δέρμα τα πρώτα βακτήρια που δρουν προστατευτικά έναντι του καρκίνου. Πρόκειται για ένα...

Μία λοίμωξη από σταφυλόκοκκο μπορεί να αποδειχτεί ακόμα και θανατηφόρα, αν τα βακτήρια εισβάλλουν βαθύτερα στο σώμα του ασθενούς...

Η δημοσίευση που έκανε στο twitter μιας νεαρή κοπέλα έχει γίνει viral, επειδή κάτι που μπορεί να συμβεί στον...

Σταφυλόκοκκος είναι μια ομάδα βακτηρίων που μπορούν να προκαλέσουν μια σειρά από ασθένειες ως αποτέλεσμα της μόλυνσης σε διάφορους...

Ο σταφυλόκοκκος είναι ένα είδος βακτηρίου που μπορεί να προκαλέσει πολλά είδη λοιμώξεων στο σώμα σας.

Η νικλοσαμίδη, ένα φάρμακο που χρησιμοποιείται για την αντιμετώπιση λοιμώξεων από παράσιτα (ταινίες) στους ανθρώπους, ρίχνεται τώρα από τους...